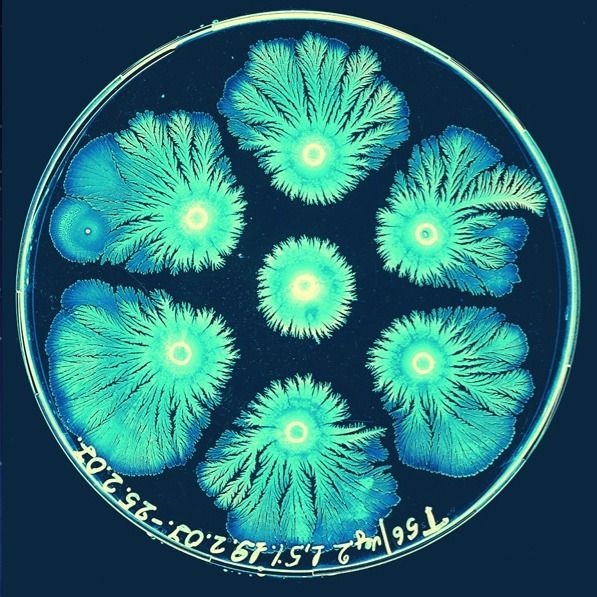

This week's paper is "Gabriel's Wedding Cake". In this paper the author describes a geometric figure that has infinite surface area but finite volume.
Imagine "a cake you can eat, but cannot frost." You can learn more here: https://t.co/30DSj2t1Se
William Jones introduced the symbol π for the ratio of a circle's perimeter to its diameter in 1706. Until then it was known as quantitas in quam cum multiflicetur diameter, proveniet circumferencia - the quantity which, when the diameter is multiplied by yields the circumference
Yesterday the @MarsRovers Opportunity mission came to an end. 😢
What started as a 90 day mission turned into 15 years of exploration of the planet Mars that lead to many ground-breaking discoveries.
Bravo @Nasa @NASAJPL!
FUN FACT
George Ellery Hale was an American astronomer passionate about telescopes. He received his first telescope when he was 14 and during his life he built 4 consecutive world's largest telescopes. The Hale telescope remained the largest telescope 40 years after his death. 🔭
These beautiful geometrical shapes are the skeletons of Radiolaria. Radiolaria are protozoa that are found as zooplankton throughout the ocean and their skeletal remains make up a large part of the cover of the ocean floor.
Microbial art 🖼
Beautiful structures formed by colonies of billions of bacteria as they adapt to hostile environments. These structures illustrate the coping strategies that bacteria have learned to employ, like cooperation through communication.
Credit Eshel Ben-Jacob
PAPER
Human and nonhuman primate meninges harbor lymphatic vessels that can be visualized noninvasively by MRI
https://t.co/OK7TGwNYaX
PAPER:
What is the profile of the mountain so that the two climbers stay always at the same height?
SOLUTION HERE: https://t.co/Qc5BEF8Pte
Apparent Paradox: This solid has a finite volume but an infinite surface area! 🤔
LEARN MORE HERE: https://t.co/I9CYsxElvU
Countries (and successor states) whose citizens have flown in space as of September 2015